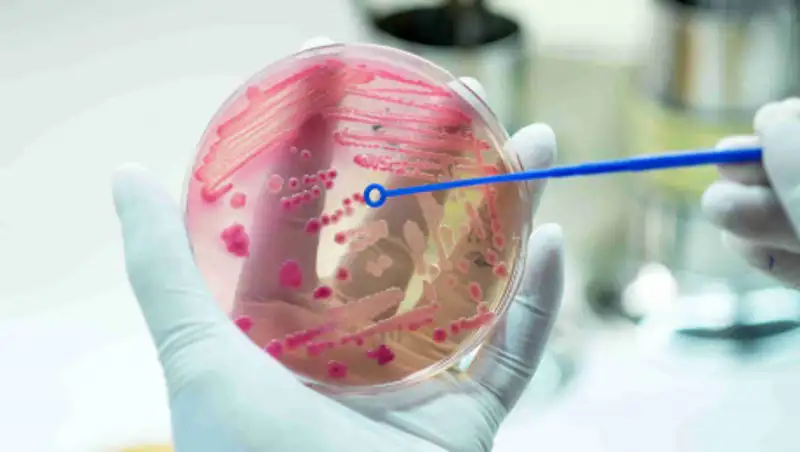
Советы медиков, как избежать заболевания менингококковой инфекцией

Инфекция горла лишила младенца конечностей
 YouTube
YouTube
В английском городе Клиторпс, графства Линкольншир, ребенок лишился конечностей после того, как подхватил инфекцию горла, передает Lenta.ru.
Мать 11-месячного Оливера Аисторпа, 23-летняя Эбигейл Уордл, заметила, что у ее сына западает родничок. Женщина испугалась, что у него обезвоживание, и обратилась за медицинской помощью. Врачи прописали ребенку анальгетик и отправили домой. Вскоре состояние младенца ухудшилось, и британке пришлось снова показать его медикам.
Специалисты обнаружили у Оливера инфекцию горла, которая привела к сепсису. Им удалось нормализовать состояние мальчика, однако они предупредили Уордл, что если Оливеру станет хуже, его не удастся спасти. Из-за промедления в диагностике сепсиса ребенку пришлось ампутировать конечности, поскольку они начали постепенно отмирать.
- Они были тяжелыми, и ему было неудобно. Оливеру было плохо. Я знаю, что это звучит странно в устах матери, но я очень хотела, чтобы их ампутировали, - рассказала Уордл.
Мальчика выписали из больницы через пять месяцев. По словам матери, ребенок привыкает к новой жизни и учится обходиться без конечностей.